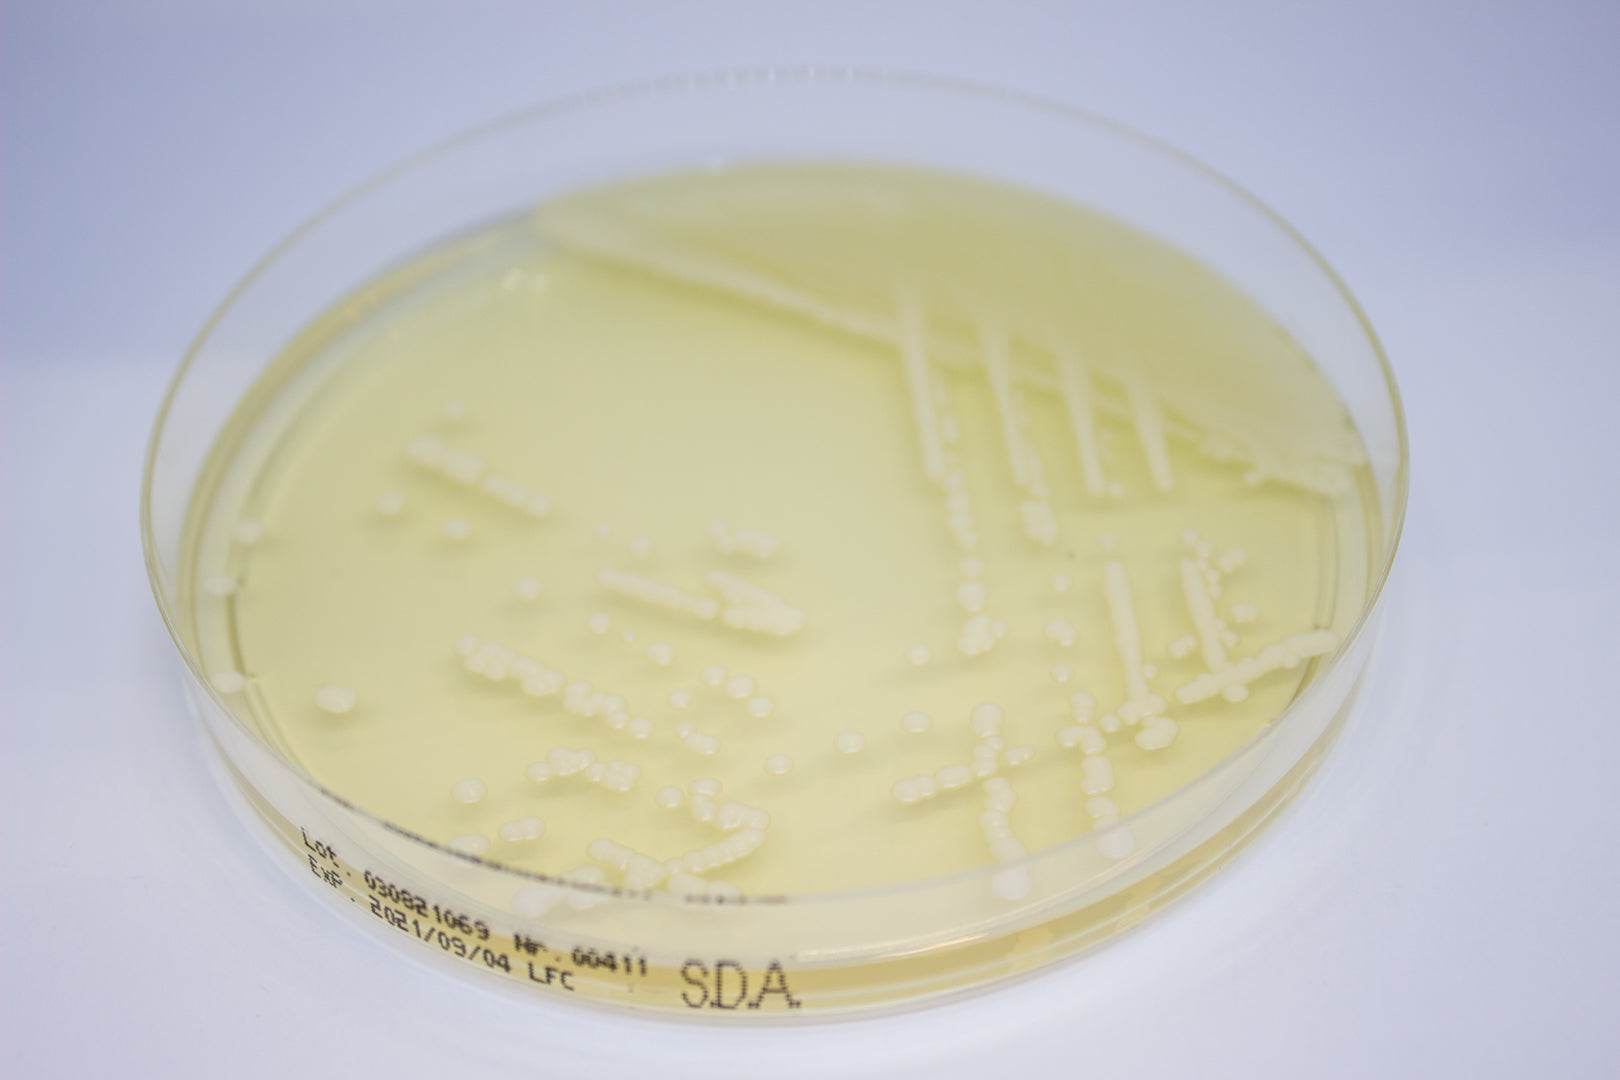
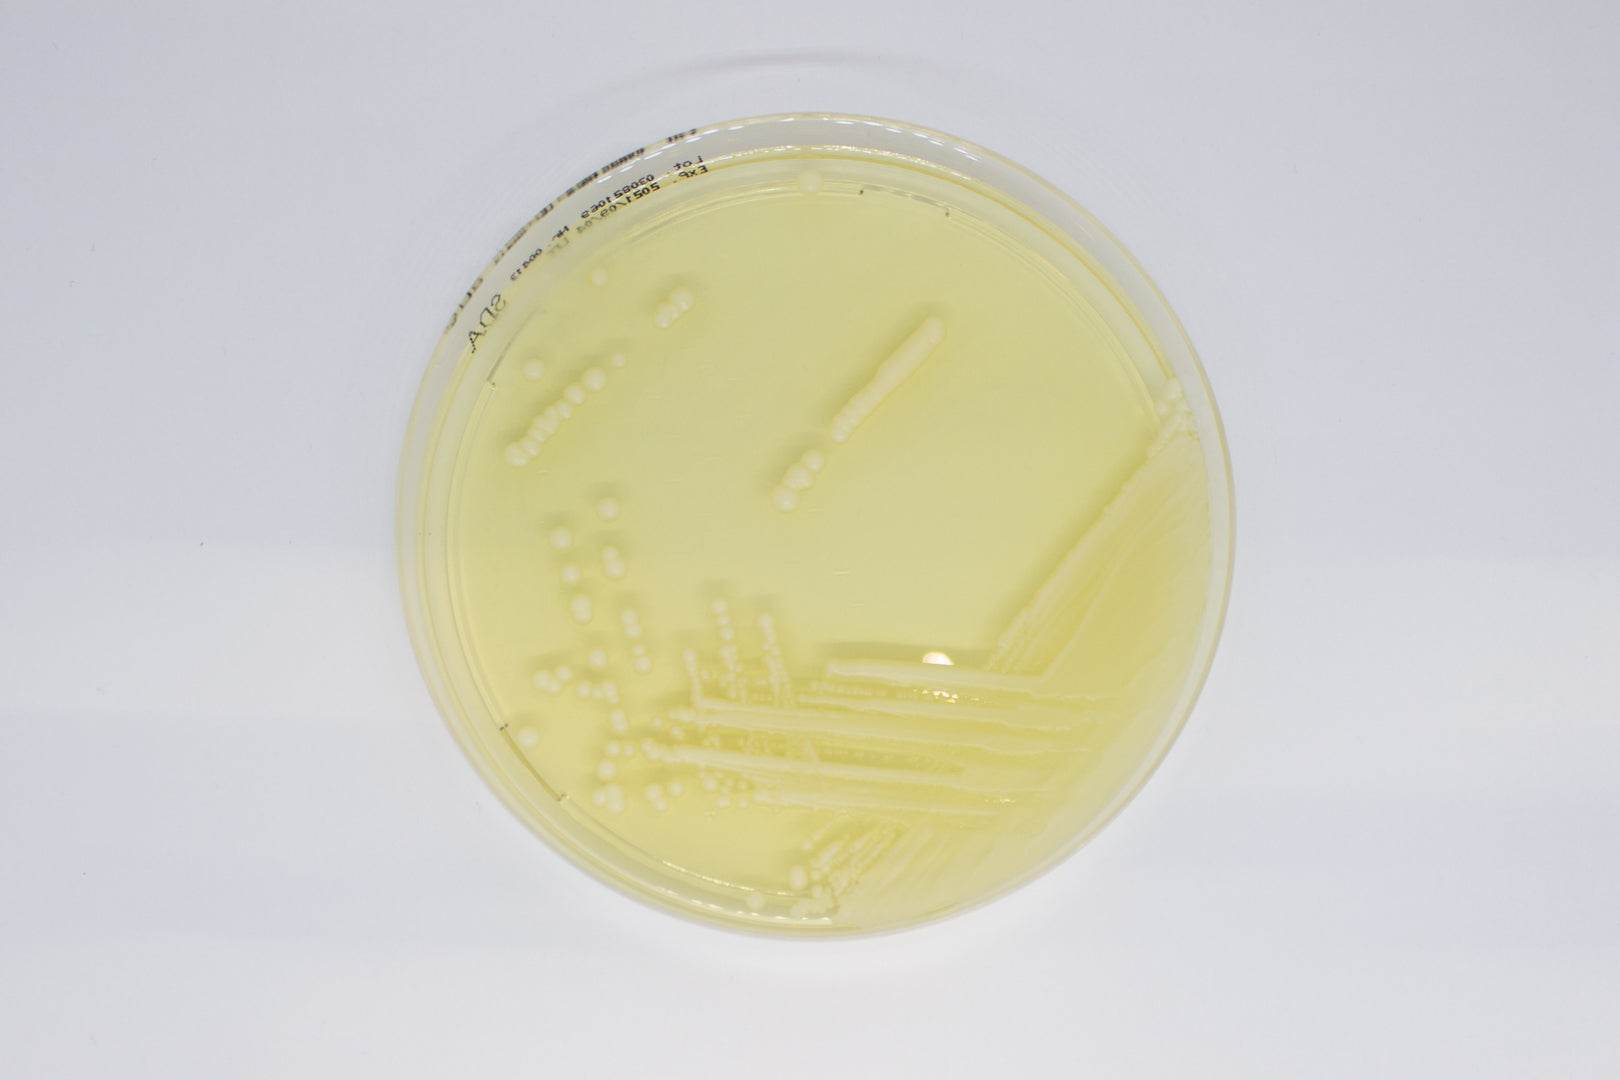
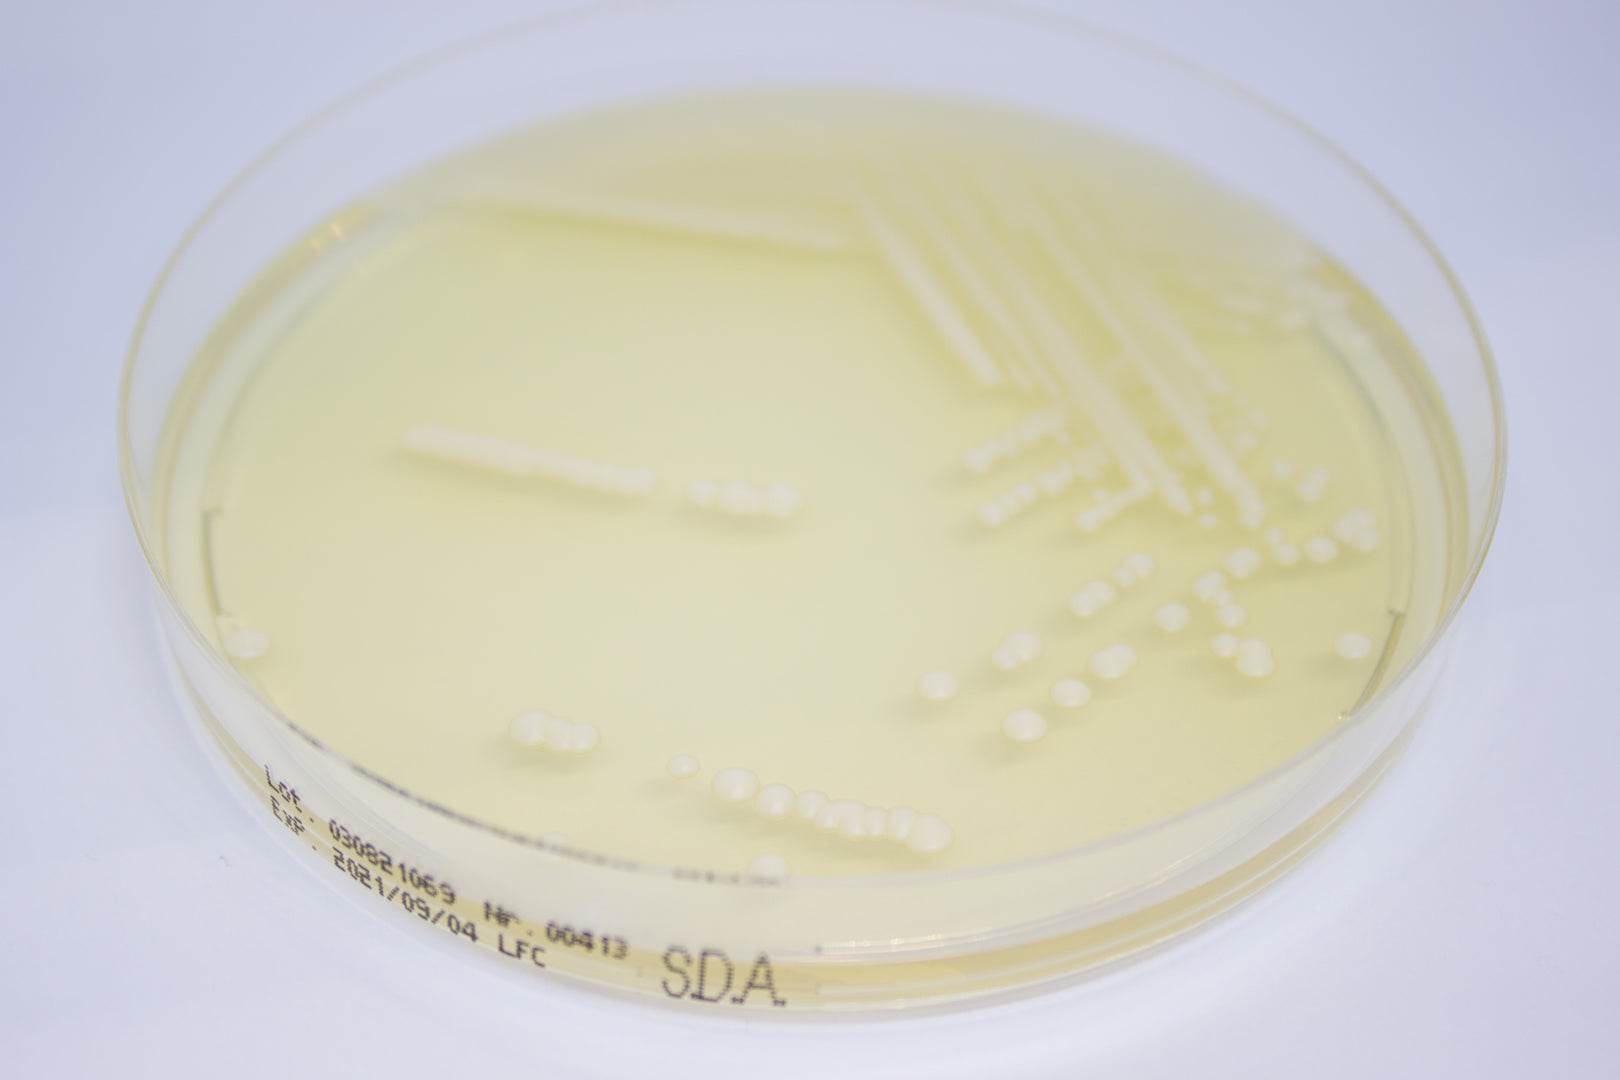

Description
ready-to-use plates
DESCRIPTION
Sabouraud Dextrose Agar (SDA) is a non-selective isolation medium used for the growth and maintenance of
pathogenic and non-pathogenic fungi from clinical and nonclinical specimens. It is also used for recovery and
total counting of yeasts and moulds in environmental monitoring.
This medium complies with EN ISO 11133 for microbiological examination of food, animal feed and water,
where it is described as the main reference medium to carry out quantitative testing on culture media intended
for fungi.
Its formula conforms to the recommendations of the harmonized method in the United States Pharmacopoeia
(USP), European Pharmacopoeia (EP) and Japanese Pharmacopoeia (JP) for the microbiological examination of
non-sterile products. The medium is also available as gamma-irradiated triple bagged plates, particularly
suitable for use in restricted areas like isolators and clean rooms.
Payment & Security
Your payment information is processed securely. We do not store credit card details nor have access to your credit card information.